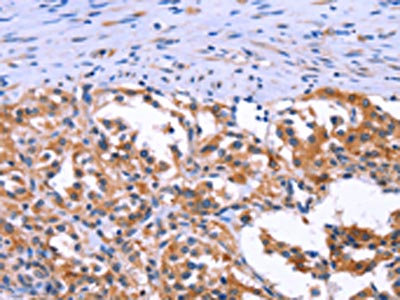

ANO1 Antibody
-
中文名稱:ANO1兔多克隆抗體
-
貨號:CSB-PA110575
-
規(guī)格:¥1100
-
圖片:
-
The image on the left is immunohistochemistry of paraffin-embedded Human thyroid cancer tissue using CSB-PA110575(ANO1 Antibody) at dilution 1/40, on the right is treated with synthetic peptide. (Original magnification: ×200)
-
Gel: 6%SDS-PAGE, Lysate: 40 μg, Lane: Human fetal brain tissue, Primary antibody: CSB-PA110575(ANO1 Antibody) at dilution 1/250, Secondary antibody: Goat anti rabbit IgG at 1/8000 dilution, Exposure time: 3 minutes
-
-
其他:
產品詳情
-
Uniprot No.:
-
基因名:ANO1
-
別名:ANO 1 antibody; ANO1 antibody; ANO1_HUMAN antibody; Anoctamin 1 antibody; Anoctamin 1 calcium activated chloride channel antibody; Anoctamin-1 antibody; Anoctamin1 antibody; Ca2+ activated Cl- channel antibody; Calcium Activated Chloride Channel antibody; Discovered on gastrointestinal stromal tumors protein 1 antibody; DOG 1 antibody; DOG1 antibody; FLJ10261 antibody; Membrane protein antibody; Oral cancer overexpressed 2 antibody; Oral cancer overexpressed protein 2 antibody; ORAOV 2 antibody; ORAOV2 antibody; TAOS 2 antibody; TAOS2 antibody; TMEM 16A antibody; TMEM16A antibody; Transmembrane protein 16A (eight membrane spanning domains) antibody; Transmembrane protein 16A antibody; Tumor amplified and overexpressed sequence 2 antibody; Tumor-amplified and overexpressed sequence 2 antibody
-
宿主:Rabbit
-
反應種屬:Human,Mouse
-
免疫原:Synthetic peptide of Human ANO1
-
免疫原種屬:Homo sapiens (Human)
-
標記方式:Non-conjugated
-
抗體亞型:IgG
-
純化方式:Antigen affinity purification
-
濃度:It differs from different batches. Please contact us to confirm it.
-
保存緩沖液:-20°C, pH7.4 PBS, 0.05% NaN3, 40% Glycerol
-
產品提供形式:Liquid
-
應用范圍:ELISA,WB,IHC
-
推薦稀釋比:
Application Recommended Dilution ELISA 1:1000-1:2000 WB 1:200-1:1000 IHC 1:25-1:100 -
Protocols:
-
儲存條件:Upon receipt, store at -20°C or -80°C. Avoid repeated freeze.
-
貨期:Basically, we can dispatch the products out in 1-3 working days after receiving your orders. Delivery time maybe differs from different purchasing way or location, please kindly consult your local distributors for specific delivery time.
-
用途:For Research Use Only. Not for use in diagnostic or therapeutic procedures.
相關產品
靶點詳情
-
功能:Calcium-activated chloride channel (CaCC) which plays a role in transepithelial anion transport and smooth muscle contraction. Required for the normal functioning of the interstitial cells of Cajal (ICCs) which generate electrical pacemaker activity in gastrointestinal smooth muscles. Acts as a major contributor to basal and stimulated chloride conductance in airway epithelial cells and plays an important role in tracheal cartilage development.
-
基因功能參考文獻:
- Bile acids stimulate Cl(-) secretion in biliary cells through activation of membrane TMEM16A channels in a process regulated by extracellular ATP and [Ca(2+) ]i . PMID: 29360145
- This will include discussion of developed knockout models that have provided much needed insight on the functional localization of TMEM16A in several epithelial tissues. Finally, this review will examine the implications of the identification of TMEM16A as it pertains to potential novel therapies in several pathologies PMID: 29748496
- Inhibition of STAT6/Anoctamin-1 activation decreased proliferation, migration, or invasion of gastric cancer cells. PMID: 29466035
- The effect of CLCA2 on ICaCC (calcium-activated chloride channel currents) was tested in HEK293 cells stably expressing calcium-activated chloride channel TMEM16A. PMID: 29758025
- TMEM16A expression was found to correlate with greater tumor size, less Bim expression, and less apoptotic activity overall in head and neck squamous cell carcinomas (HNSCCs). PMID: 28899969
- resveratrol (RES) might be a promising drug for the treatment of gastrointestinal hypomotility. As RES was able to induce TMEM16A channel activation, TMEM16A can be added to the list of RES drug targets. PMID: 28852814
- results indicate that the enhanced activity in chimeric channels is due to altered interaction between the carboxy-terminus and the first intracellular loop in the TMEM16A homo-dimer. Mimicking this perturbation with a small molecule could be the basis for a pharmacological stimulation of TMEM16A-dependent Cl(-) transport. PMID: 27929144
- ANO1 overexpression associated with the high expression of EGFR can be a predictive marker of recurrence after surgery in non-small cell lung cancer PMID: 28299581
- Study demonstrated that segment a is a critical domain for the surface expression of ANO1, and identified 14-3-3gamma as a binding partner for this segment enhancing the surface expression of ANO1. In addition, gene silencing of 14-3-3gamma and/or ANO1 inhibited migration and invasion of these glioblastoma cell lines. PMID: 27212225
- lipids and fatty acids regulate TMEM16A channels through a membrane-delimited protein-lipid interaction. PMID: 29277655
- knockdown of ESYT1 (and family members ESYT2 and ESYT3) significantly decreased ANO1 current density. PMID: 29154949
- labeled proteins were imaged and showed that hTMEM16A resides in the plasma membrane as dimer only and is not present as monomer. PMID: 28559167
- ANO1 overexpression promotes cancer cell proliferation and migration. Genetic or pharmacological inhibition of ANO1 induces apoptosis and cell cycle arrest at G1 phase in different types of epithelium-originated cancer cells. PMID: 27732935
- Furthermore, the overexpression of ANO1 has a significant effect on both distant metastasis and poor prognosis. Our results suggest a potential role for ANO1 in CRC through miR-132. PMID: 26868958
- Data show that ANO1 in peripheral blood is of clinical potential for monitoring recurrence and evaluating therapeutic efficacy of imatinib for GIST patients. PMID: 27153560
- Results show that TMEM16A is a direct target of miR-381 and its expression in gastric neoplasm is inversely correlated to that of miR-381.TMEM16A mediates the functional effects of miR-381 on migration and invasion in gastric cancer cells. PMID: 28193228
- Positive anoctamin 1 (ANO1) is a promising biomarker to predict the unfavorable outcome for ESCC patients and disease progression of precancerous lesions. PMID: 27016410
- TMEM16A expression was enhanced by 24-h treatment of IL-4 in human nasal epithelial cells. PMID: 28546154
- findings demonstrate that Ca2+ influx via store-operated CRAC channels is essential for CaCC activation, chloride secretion, and sweat production in humans and mice. PMID: 27721237
- TMEM16A activation as a sequential, direct, and Vm-dependent binding. PMID: 27138167
- Ano1(0) without EAVK [Ano1(0)DeltaEAVK] has reduced sensitivity for intracellular calcium, attributable to slower kinetics. Differential expression of EAVK may function as a calcium-sensitive switch in the human stomach. PMID: 28336549
- Gains of ANO1 is associated with oropharyngeal squamous cell carcinoma. PMID: 27750372
- DOG1 is a novel marker for identifying intercellular canaliculi and is a potential immunomarker of myoepithelial cells specific to mammary glands, anogenital mammary-like glands and tumors originating therein. PMID: 27506854
- Increase in TMEM16A activity occurred within minutes of exposure to CLCA1 or after a short treatment with nocodazole, consistent with the hypothesis that CLCA1 stabilizes TMEM16A at the cell surface by preventing its internalization. PMID: 28420732
- These results suggest that ANO1 Cl(-) channels may function as a transcriptional regulator of HER2, and ANO1 inhibitors have potential in the treatment of BCA patients with resistance to HER2-targeted therapy. PMID: 27838298
- Endogenous ANO1 was associated with COPB1 in U251 glioblastoma cells, and silencing of COPB1 enhanced surface expression and whole-cell currents of ANO1 in these cells. Taken together, these data suggest that COPB1 negatively regulates ANO1 surface expression. PMID: 27207835
- targeting TMEM16A improves response to biological therapies targeting EGFR/HER family members PMID: 28177558
- STAT6-TMEM16A-ERK1/2 signal pathway and TMEM16A channel activity are required for the IL-13-induced TMEM16A mediated mucus production PMID: 27588910
- DOG1 positivity was detected in most gastrointestinal stromal tumors and its overexpression was related with adverse prognosis PMID: 28044310
- DOG1 positivity might be a candidate marker to support KIT and PDGFRA mutations. PMID: 27178821
- Results showed that DOG1 expression was consistently positive in breast myoepithelial cells (MEC), and is then a useful MEC marker providing more sophisticated information when diagnosing uncertain cases in the breast. PMID: 27041791
- ANO1 on ICCs makes a key contribution to generation and regulation of pacemaker electrical slow-wave activity. PMID: 26510736
- Data show that calcium-activated chloride channel TMEM16 overexpression correlates with decreased survival in human papilloma virus -negative tumors. PMID: 26563938
- DOG1 was expressed in 66% of CD117(+) GISTs and highly associated with tumor size and the rate of wild-type tumors PMID: 26867653
- DOG1 positivity in select non-GIST tumors. PMID: 26678977
- Our results indicated that both the electrical property and the size of the side-chain at residue 447 have significant effects on Ca(2+) dependent gating of TMEM16A. PMID: 26481648
- ANO1 expression and gene amplification showed no significant associations with clinicopathological parameters in HNSCC. PMID: 26498851
- DOG1 is a sensitive marker in the diagnosis of acinic cell carcinoma PMID: 26464669
- TCGA analysis showed that ANO1 and FADD, located at 11q13, were co-expressed at transcript level and significantly associated with overall and disease-free survival PMID: 26808319
- Aberrant c-KIT and DOG-1 expressions in CRC are rare events, either in NMA or MA. PMID: 26272691
- Anoctamin and pendrin are two plausible candidates as mediators of apical iodide efflux--{review} PMID: 26313899
- our findings provide evidence that ANO1 overexpression contributes to tumor growth and invasion of lung cancer; and suppressing ANO1 overexpression may have therapeutic potential in lung cancer therapy PMID: 26305547
- DOG1 expression was found in low-grade fibromyxoid sarcoma, highlighting the potential for diagnostic confusion with gastrointestinal stromal tumors. PMID: 26135531
- DOG-1, VEGFA and p16 are expressed in cutaneous basal and squamous cell carcinomas PMID: 26429157
- PKCalpha is coupled to ATP-stimulated TMEM16A activation in biliary epithelial cells. PMID: 26542395
- gastrointestinal stromal tumors with mutations in the DOG1 gene were not found PMID: 26191287
- Pancreatic ductal adenocarcinoma cell lines showed an upregulation of ANO1 on mRNA and protein levels. ANO1 is the main constituent of CaCC current in PDAC cells. PMID: 25163766
- TMEM16A overexpression promotes invasion and metastasis in gastric cancer. PMID: 25839162
- ANO1 and EGFR form a functional complex that jointly regulates head & neck squamous cell carcinoma cell proliferation. PMID: 25823819
- examined TMEM16A protein interactions with calmodulin and CaMKIIdelta likely cause efflux of chloride, thus resulting in increased vascular resistance by increasing vascular wall tone in long-standing hypertension PMID: 25914185
顯示更多
收起更多
-
亞細胞定位:Cell membrane; Multi-pass membrane protein. Cytoplasm.
-
蛋白家族:Anoctamin family
-
組織特異性:Broadly expressed with higher levels in liver, skeletal muscle and gastrointestinal muscles.
-
數(shù)據(jù)庫鏈接:
Most popular with customers
-
-
YWHAB Recombinant Monoclonal Antibody
Applications: ELISA, WB, IHC, IF, FC
Species Reactivity: Human, Mouse, Rat
-
Phospho-YAP1 (S127) Recombinant Monoclonal Antibody
Applications: ELISA, WB, IHC
Species Reactivity: Human
-
-
-
-
-